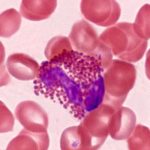
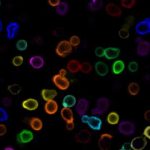

INDIAN INSTITUTE OF MORPHOLOGY

Introduction
The Indian Institute of Morphology is dedicated to advancing the understanding of form, structure, and organization across multiple scientific fields. Morphological study at the Institute spans mathematics, physics, chemistry, biology, and medicine, establishing an integrative framework that links fundamental science with applied research and clinical practice. By exploring the universal principles of structure—from geometric and molecular arrangements to the organization of living systems—the Institute aims to foster innovation and discovery that improve human health and knowledge. With a strong focus on imaging technologies and interdisciplinary collaboration, the Institute prepares future scientists and clinicians to address complex challenges through a comprehensive morphological perspective. Its scope and future lie in bridging theory with practical applications, driving breakthroughs in diagnostics, therapeutics, education, and societal impact, ultimately positioning the Institute as a global leader in morphological sciences.
FORMATION AND A SHORT HISTORY OF THE INDIAN INSTITUTE OF MORPHOLOGY TRUST (IIMT)
The INDIAN INSTITUTE OF MORPHOLOGY TRUST ( IIMT ) was formally registered with the Government of India on the 7th of May 2013.
- DR TAMOJIT GHOSH : Settlor of the Trust
- Mr INDRANIL DASGUPTA : Trustee
- Prof PRANTAR CHAKRABARTI : Trustee
On 1st September 2025, after 12 years of being Trustee, Mr Indranil Dasgupta tendered his resignation due to heavy working responsibilities in his professional corporate life. Prof Avijit Hazra ( Professor of Pharmacology and Dean of Student Affairs in the Institute of Post Graduate Medical Education and Research – IPGMER ) accepted the vacant position and stepped into his place. Mr Dasgupta will be severely missed as he was a founder Trustee and an extremely erudite man. Prof Avijit Hazra was selected for his long and exemplary academic career and his remarkable administrative acumen. The IIMT has been blessed by Mr Indranil Dasgupta’s initial involvement and Prof Avijit Hazra acceptance of the position of Trustee. This allows the Trustee Board to move into better areas of governance, academic activities and prominence.
The Trust has a very dedicated and serious mission that you will find in the mission statement of the Indian Institute of Morphology
Registration Details
The INDIAN INSTITUTE OF MORPHOLOGY was conceived by Dr Tamojit Ghosh and is run by the Indian INSTITUTE OF MORPHOLOGY TRUST ( IIMT ). The IIMT was registered with the Government of India on 7-5 2013 in the Assurances II building Kolkata 700001.
Details of this registration include :
OFFICE AND ENDORSEMENT NUMBER :
OFFICE OF THE A.R.A III KOLKATA :
ENDORSEMENT FOR AED NUMBER IV – 03172 OF 2013
( SERIAL NUMBER 05620 OF 2013 AND QUERY NO L000009387 OF 2013)
REGISTRATION DETAILS INCLUDE :
Certificate of Registration under section 60 and Rule 69 :
Registered in Book – IV , CD Volume 5 Page from 3886 to 3904 being No 03172 for the year 2013
REGISTRATION DETAILS IN NGO DARPAN PORTAL OF THE GOVERNMENT OF INDIA :
DARPAN ID – WB/2025/0817027 REGISTRATION DATE : 15-9-2025
REGISTRATION AUTHORITY : ADDITIONAL REGISTRAR OF ASSURANCES IIII
GOVERNMENT OF INDIA ACT : THE INDIAN TRUSTS ACT 1882
Imaging is basic to morphological assessment
Morphological study of size, shape and function is essential at microscopic level. This science in called Stereology and has developed into a major field of measurement at higher resolution microscopy. Essays and details on Stereology are written under the ESSAYS IN MORPHOLOGY menu on header.
7th May 2013
BIRTH OF IIMT
DAYS LOGGED IN JOURNEY
REGISTERED WITH
GOVERNMENT OF INDIA
Events
There are many new and old named morphology conferences being held worldwide . We encourage all involved with INDIAN INSTITUTE OF MORPHOLOGY participitation to all involved with the Institute to travel and participate
SCOPE OF MORPHOLOGY STUDIES IN EVERYDAY LIFE
Morphological studies, which focus on the form, structure, and organization of living and non-living systems, have a wide scope in everyday life. In biology, understanding the morphology of plants and animals helps in identifying species, improving agriculture, and diagnosing diseases. For instance, leaf shape or seed structure guides food cultivation, while cellular morphology aids in medical imaging and pathology. In linguistics, morphology—the study of word formation—enhances communication, literacy, and language learning. In materials science, examining the morphology of crystals, polymers, or nanoparticles contributes to the development of stronger building materials, electronics, and medicines. Even in art and architecture, morphological principles guide design, balance, and aesthetics. From analyzing facial structures in forensic science to studying traffic patterns or cloud formations, morphology provides insights into patterns and functions. Thus, morphological studies bridge science, technology, culture, and daily experiences, making them deeply relevant to human life.